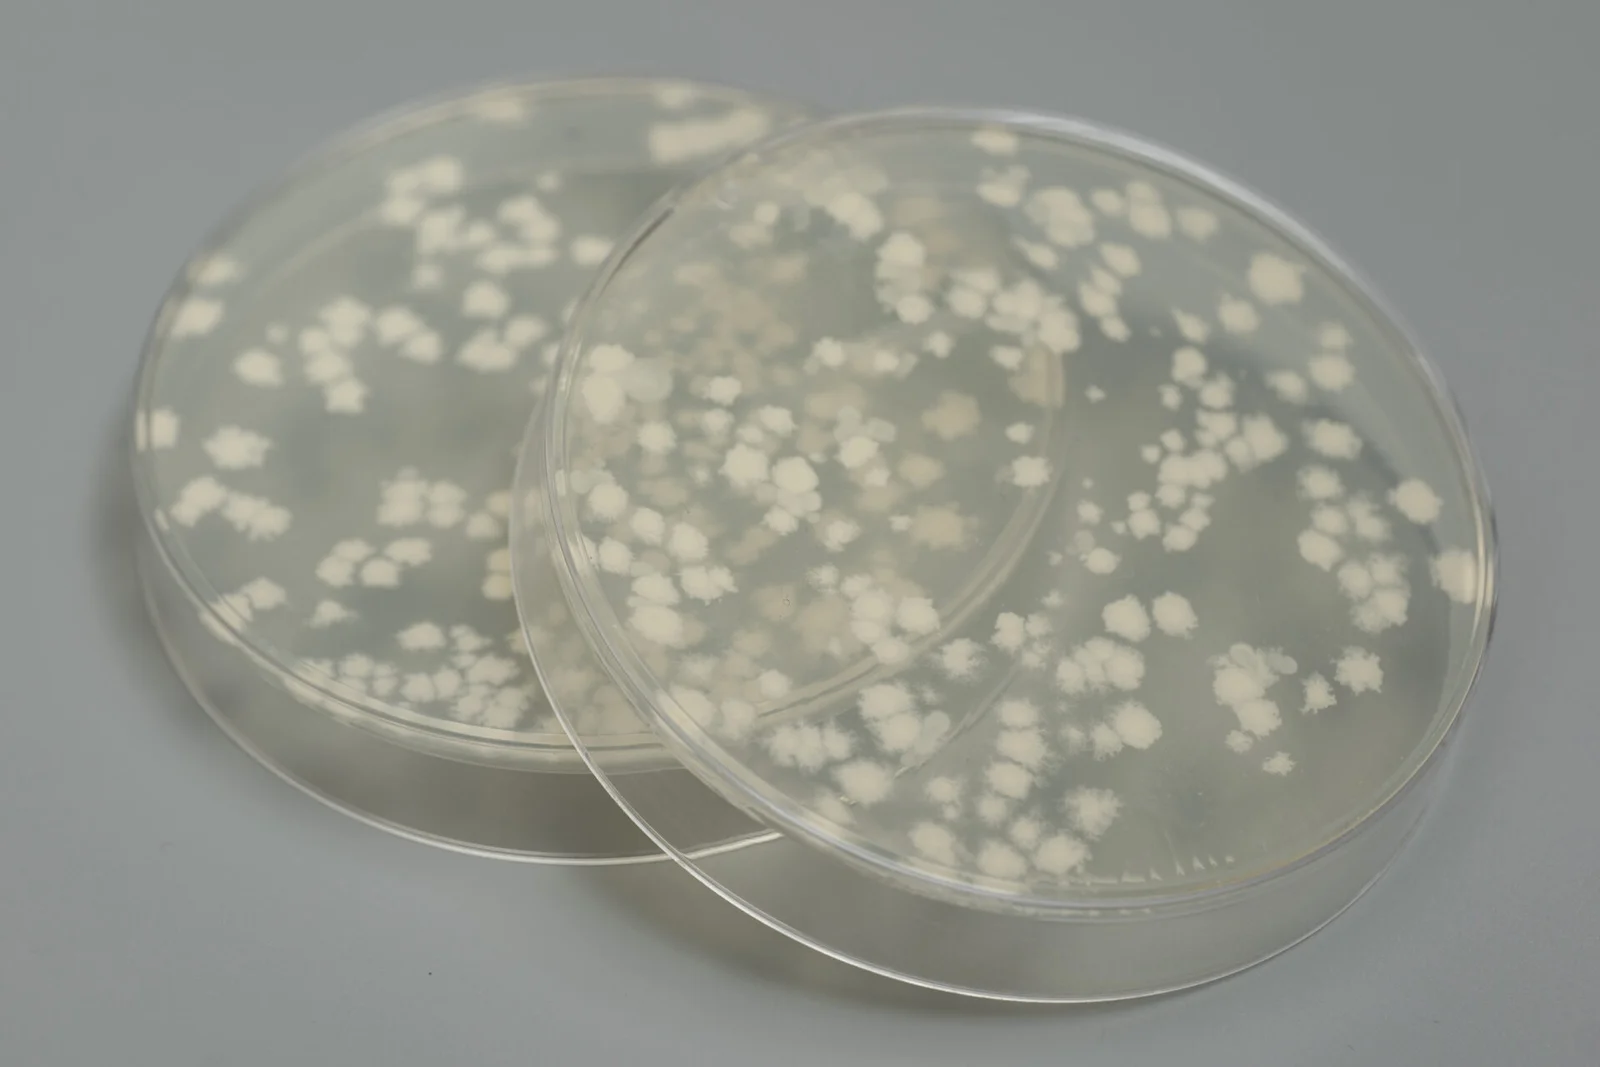
Sveiku švarumu Sveiku švarumu

Patarimai ir naujienos
Medikų verdiktas: sterili švara namuose – didesnė vaikų alergijų rizika

Ko gero pirmą kartą žmonijos istorijoje gyvename itin švariuose namuose, o tvarkai palaikyti kasdien naudojame įvairius valiklius, skalbiklius ir purškiklius. Medikai kelia klausimą, ar toks rūpestis švara tikrai reiškia sveikesnę aplinką?
Moksliniai tyrimai rodo, kad perdėtas sterilumas ir agresyvios cheminės valymo priemonės gali pakenkti natūraliai mikrobiotai ir silpninti organizmo, ypač vaikų, imunitetą.
Aplinkos mikrobiota – tai natūralūs mikroorganizmai, gyvenantys mūsų aplinkoje: ore, ant paviršių, augaluose, gyvūnuose ir dirvožemyje. Pedantiškas švarinimasis, dažnas antibakterinių valiklių naudojimas, mažesnis kontaktas su gamta, gyvūnų įvairovės stoka – visa tai smarkiai mažina mūsų kontaktą su natūraliais mikrobais.
Dr. Indrė Plėštytė, vaikų gydytoja, biomedicinos mokslų daktarė, klinikų „Mama, aš sergu“ vadovė, pabrėžia, kad natūrali mikrobiota yra nematoma organizmo apsauga, kuria būtina pasirūpinti ir išsaugoti.
„Tyrimai rodo, kad vaikų, augančių per švarioje aplinkoje, mikrobiotos įvairovė yra mažesnė, o tai tiesiogiai siejama su padidėjusia alergijų, autoimuninių ligų ir net psichikos sutrikimų rizika. Pasaulio sveikatos organizacija (PSO) įspėja: per mažas kontaktas su natūraliais mikrobais silpnina imuninės sistemos „mokymosi“ gebėjimus. Ištirta, kad vaikai, augę kaimo vietovėse ar kontaktavę su gyvūnais, 50–60 proc. rečiau serga astma ar alergijomis („The New England Journal of Medicine“, 2016), o tyrimai su gyvūnais rodo, kad buitinės cheminės medžiagos, pvz., triklozanas, keičia žarnyno mikrobiotą ir gali skatinti uždegiminius procesus organizme“, – mokslininkių tyrimų išvadas vardija medikė.
Pavojus vaikų sveikatai
Nors tėvai kruopščiai rūpinasi namų higiena, nes nori, kad jų atžalos gyventų tvarkingoje aplinkoje, tačiau naujausi tyrimai atskleidžia vis daugiau nemalonių faktų apie įprastų buities chemikalų keliamą poveikį vaikų sveikatai. Mokslininkai nustatė, kad dažnai kasdieniuose valikliuose aptinkamos medžiagos, tokios kaip ftalatai, antipirenai ir lakiųjų organinių junginių (LOJ) garai, gali neigiamai paveikti vaikų vystymąsi.
Pastebėta, kad įprastų valymo priemonių naudojimas yra siejamas su vaikų kvėpavimo takų ligomis. Amerikos Plaučių Asociacija nurodo, kad valikliuose esantys LOJ gali sukelti lėtinius kvėpavimo sutrikimus, alergines reakcijas ir galvos skausmus.
Dr. I. Plėštytė atkreipia dėmesį, kad kasdien buityje naudojamose valymo priemonėse esantys chemikalai gali neigiamai veikti vaikų sveikatą. Chemikalai gali tapti kvėpavimo takų ligų ar astmos priežastimi, sutrikdyti žarnyno mikroflorą bei endokrininę sistemą.
„Buitinės valymo priemonės yra antra dažniausia netyčinio vaikų iki 6 metų amžiaus apsinuodijimo priežastis. Pvz., 2018 m. apie 44,2 proc. visų netyčinių apsinuodijimų atvejų JAV buvo užfiksuoti vaikams iki 6 metų, o valymo priemonės sudarė 10,7 proc. visų vaikų apsinuodijimų atvejų“, – vardija medikė.
Sveikos alternatyvos
Suprantama, kad rūpintis namų švara būtina, tačiau svarbu išsirinkti rinkamas priemones, kurios ne tik padėtų palaikyti švarą, bet ir būtų saugios vaikams bei draugiškos aplinkai. Viena iš saugių alternatyvų – valymo produktų linija „Sveiku švarumu“, sukurta kartu su dr. I. Plėštytė, vaikų gydytoja, biomedicinos mokslų daktare.
Pagal patentuotą technologiją iš natūralių ingredientų Lietuvoje pagamintos priemonės efektyviai valo paviršius, bet, svarbiausia, nekenkia sveikatai. Tyrimais įrodyta, kad valikliai su probiotikais ne naikina mikroorganizmus, o atkuria sveiką mikroflorą ant paviršių.
Atraskite aukštos kokybės valiklius
Probiotikų svarba mūsų gyvenime. Moksliniais tyrimais įrodyta, kad probiotikai yra naudingi žmogaus sveikatai, teigiamai veikia žarnyno mikrofloros pusiausvyrą, apsaugo organizmą nuo žarnyno blogųjų bakterijų, stimuliuoja imuninę sistemą, padeda greičiau pasveikti.